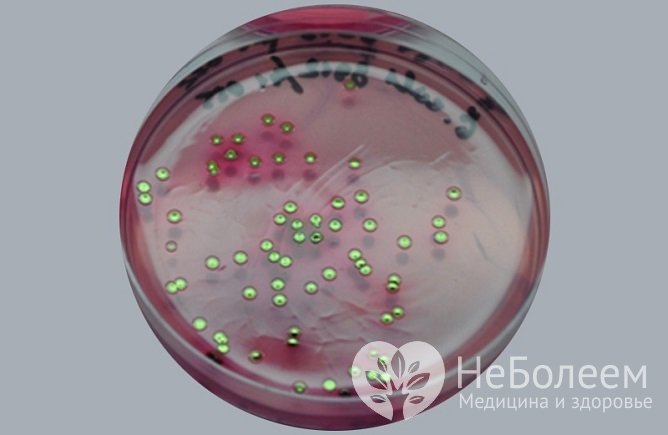
Эшерихии - наиболее распространенный возбудитель кишечной инфекции у детей

Воспользуйтесь поиском по сайту:
Кишечная инфекция у детей
Содержание статьи:
Кишечная инфекция у детей – группа заболеваний различной этиологии, протекающих с преимущественным поражением пищеварительного тракта, токсической реакцией и обезвоживанием организма.
Восприимчивость к кишечной инфекции у детей в несколько раз выше, чем у взрослых, заболевание характеризуется ярко выраженными клиническими признаками, может сопровождаться ослаблением иммунитета, развитием ферментной недостаточности, дисбактериоза кишечника. Кишечные инфекции у детей занимают второе место в структуре инфекционной заболеваемости после острых респираторных вирусных инфекций. Широкая распространенность кишечных инфекций среди детей вызвана высокой контагиозностью и распространенностью возбудителей, их устойчивостью к воздействию факторов внешней среды, возрастными особенностями строения и функционирования пищеварительной системы, функциональным несовершенством защитных механизмов, а также в недостаточной степени привитыми и закрепленными навыками гигиены.
При тяжелых формах кишечных токсикозов у детей возможно развитие отека легких, острой почечной и острой сердечной недостаточности.
В мире ежегодно регистрируется примерно 2 млн летальных исходов от острых кишечных инфекций, преимущественно среди детей до 5 лет.
Причины
Возбудителями кишечных инфекций у детей могут быть:
- бактерии (шигеллы, сальмонеллы, диареегенные эшерихии, иерсинии, кампилобактеры, стафилококки, клебсиеллы и др.) и их токсины (ботулотоксин);
- вирусы (рото-, адено-, энтеро-, астро-, короно-, торо-, калицивирусы и др.);
- простейшие (лямблии, криптоспоридии, амебы, бластоцисты и др.).
Проникновение инфекции в организм при кишечных инфекциях происходит, главным образом, при употреблении инфицированных продуктов питания (алиментарным путем), загрязненной воды (водным путем), через загрязненные руки, посуду, игрушки, предметы обихода (контактно-бытовым путем). Кишечные инфекции вирусной этиологии могут передаваться и аэрогенным (воздушно-капельным) путем. Вирусы вызывают наибольшее число случаев кишечных инфекций у детей до 5 лет.
У детей с ослабленным иммунитетом возможно эндогенное инфицирование условно-патогенной микрофлорой (стафилококки, клебсиеллы, протей, клостридии и др.).
Формы кишечной инфекции у детей
Кишечные инфекции классифицируют по происхождению:
- бактериальные (дизентерия, сальмонеллез, холера, ботулизм, стафилококковое пищевое отравление, иерсиниоз, брюшной тиф, эшерихиоз, др.);
- вирусные (ротавирус, аденовирус, энтеровирус, реовирус, коронаровирус, др.);
- протозойные (лямблиоз, балантидиаз, амебиаз, др.).
До получения результатов лабораторных исследований заболевания классифицируют по локализации патологического процесса (колит, энтероколит, гастрит, гастроэнтерит, энтерит, гастроэнтероколит). Кроме локализованных форм инфекции, у детей могут развиваться генерализованные формы с распространением возбудителей за пределы кишечного тракта.
Эшерихиозами болеют преимущественно дети раннего возраста, находящиеся на искусственном вскармливании.
В зависимости от механизма развития, способности к инвазии и наличия сходных факторов патогенности выделяют следующие типы кишечных инфекций:
- инвазивные;
- секреторные;
- осмотические;
- смешанные.
В основе патогенеза кишечных инфекций инвазивного типа лежит воспалительный процесс в пищеварительном тракте. Возбудители (сальмонеллы, шигеллы, кампилобактерии, энтероинвазивные эшерихии) проникают в эпителиоциты, вызывая воспаление слизистой оболочки, накопление эндогенных токсических веществ, нарушение гомеостаза.
В основе патогенеза кишечных инфекций неинвазивного (секреторного) типа лежат нарушение реабсорбции воды и электролитов и усиление секреторной активности эпителия тонкой кишки. Возбудителями секреторных кишечных инфекций могут быть энтеротоксигенные эшерихии, энтеропатогенные эшерихии, холерный вибрион.
Источник: hemltd.ru
Источник: hemltd.ruОсновой появления кишечных инфекций осмотического типа является дисахаридазная недостаточность, бродильный процесс и дегидратация за счет нарушения всасывания воды и электролитов в кишечнике. Как правило, они имеют вирусную этиологию.
По особенностям симптоматики течение кишечной инфекции у детей может быть типичным и атипичным.
С учетом степени поражения желудочно-кишечного тракта, интоксикации и обезвоживания типичные кишечные инфекции протекают в легкой, средней и тяжелой форме, а атипичные – в стертой и гипертоксической.
В зависимости от длительности течения кишечная инфекция может быть:
- острая (до 1,5 месяцев);
- затяжная (свыше 1,5 месяцев);
- хроническая (свыше 5-6 месяцев).
Симптомы кишечной инфекции у детей
Клинические симптомы кишечных инфекций у детей связаны с разрушением клеток слизистой кишки, а также нарушением пищеварения и проявляются двумя синдромами: кишечным и инфекционно-токсическим (синдромом общей интоксикации).
Тяжесть кишечной инфекции у детей во многом определяется объемом потери жидкости.
Главным симптомом при любой форме кишечной инфекции является диарея (неоднократный жидкий стул).
Другие признаки:
- тошнота, рвота;
- вялость, слабость;
- потеря аппетита;
- повышенная температура тела;
- боль, урчание в животе;
- примесь крови в каловых массах;
- нарушения дыхания;
- снижение массы тела.
Опасность представляет обезвоживание, развивающееся вследствие потери жидкости с обильными рвотными и каловыми массами. Его признаки:
- запавший родничок у грудного ребенка;
- сухость кожи и слизистых оболочек;
- снижение диуреза;
- повышенная жажда;
- запавшие сухие глаза;
Клиническая картина некоторых кишечных инфекций имеет особенности.
Дизентерия у детей характеризуется общей интоксикацией, лихорадкой, рвотой, нарушением функций ЦНС, сердечно-сосудистой системы и колитическим синдромом (притупообразные боли в животе, диарея, наличие в кале примесей слизи и крови, спазм сигмовидной кишки, боли в области прямой кишки).
Ротавирусная инфекция высококонтагиозна, клиническая картина проявляется гастроэнтеритом, поражение ЖКТ сочетается с катаральными явлениями (ринитом, гиперемией зева, покашливанием, першением в горле).
 Источник: babyzzz.ru
Источник: babyzzz.ruСимптоматика сальмонеллеза зависит от формы заболевания. Типичная (желудочно-кишечная) форма встречается наиболее часто и может протекать в виде гастрита, панкреатита, энтерита, аппендицита, пиелонефрита, холецистита, гастроэнтероколита. Стул жидкий, обильный, буро-зеленого оттенка, с примесью слизи и крови. Атипичная форма может иметь септическое, тифоподобное, токсико-септическое (у новорожденных), стертое и бессимптомное течение.
Выявление кишечной инфекции у детей до пяти лет является основанием для госпитализации в детское инфекционное отделение стационара.
Эшерихиозами болеют преимущественно дети раннего возраста, находящиеся на искусственном вскармливании. Заболевание имеет постепенное начало с появлением диареи, рвоты или срыгиваний в последующие три-пять дней. Температура тела субфебрильная или нормальная. Стул водянистый, желто-оранжевого оттенка, с примесью слизи. Симптомы болезни нарастают в течение 3-5 дней. Заболевание может протекать в трех клинических вариантах (холероподобный синдром, легкий энтерит, возникающий на фоне ОРЗ у детей раннего возраста и пищевая токсикоинфекция).
Стафилококковая кишечная инфекция у детей может быть первичной и вторичной. Течение первичной инфекции характеризуется диареей, токсикозом, рвотой. Стул водянистый, с примесью слизи, зеленоватого оттенка. При вторичной стафилококковой инфекции кишечные симптомы развиваются на фоне основного заболевания (пневмонии, ангины, гнойного отита, стафилодермии и др.).
Читайте также:4 вида веществ, снижающих защитные силы организма
Диагностика кишечной инфекции у детей
Диагностика кишечных инфекций у детей начинается с оценки эпидемиологического анамнеза заболевания. Выясняется источник инфекции (контакт с больным, семейный очаг заболевания, продукты питания, вода), механизм передачи возбудителя, распространенность поражения, интенсивность проявления основных клинических симптомов. Особое значение имеет точность оценки степени дегидратации организма, так как тяжесть кишечной инфекции у детей во многом определяется объемом потери жидкости. Оцениваются гемодинамические показатели (частота и наполнение пульса).
Клинические симптомы кишечных инфекций у детей проявляются двумя синдромами: кишечным и инфекционно-токсическим.
Для подтверждения диагноза используют лабораторные исследования:
- бактериологические исследования кала, а в тяжелых случаях мочи и ликвора – с целью идентификации возможного бактериального возбудителя;
- копрологический метод – позволяет уточнить локализацию процесса в ЖКТ;
- вирусологические методы (ИФА, КОА, РАЛ) – применяются для выявления возможного вирусного возбудителя;
- серологические методы (РТГА, РПГА) – позволяют по выявлению и нарастанию титра антител в крови определить тип возбудителя и остроту процесса.
Дифференциальная диагностика проводится с панкреатитом, острым аппендицитом, дискинезией желчевыводящих путей, лактазной недостаточностью.
Лечение кишечных инфекций у детей
Выявление кишечной инфекции у детей до пяти лет является основанием для госпитализации в детское инфекционное отделение стационара.

- устранение этиологического агента (антибактериальные, противовирусные, противопаразитарные препараты);
- выведение накопившихся токсических продуктов (сорбенты, пробиотики, специфические антитела и сыворотки);
- проведение регидратационной терапии, восстановление водно-электролитного баланса (глюкозо-солевые растворы для оральной и парентеральной регидратации), кислотно-щелочного баланса, регуляторных механизмов, гемодинамики;
- восстановление функций кишечника с помощью диетотерапии.
С целью профилактики ДВС-синдрома в схему терапии включают средства для нормализации тонуса периферических сосудов, улучшения микроциркуляции, снижения агрегации тромбоцитов, уменьшения гипоксии и ацидоза тканей.
Эффективность проведенной комплексной терапии оценивают по клиническим критериям и клинико-лабораторным данным.
В острой фазе заболевания назначают перерыв в питании (водно-чайную паузу) до стихания рвоты и диареи. У детей, находящихся на естественном вскармливании, кормление грудным молоком не прекращают, при искусственном вскармливании назначают небольшой перерыв. После разгрузки и проведения оральной регидратационной терапии начинают дозированное кормление. Необходима правильная организация лечебного питания, рацион должен быть сбалансирован по пищевым и биологически активным веществам, составлен с учетом тяжести кишечной инфекции, интенсивности и характера кишечных дисфункций.
Диета при кишечной инфекции у детей требует уменьшения суточного объема потребляемой пищи на 30–50%, увеличения кратности кормлений, использования смесей, обогащенных защитными факторами. При улучшении состояния ребенка объем пищи увеличивают ежедневно на 100-150 мл, дробно распределяя это количество на каждое кормление. Пища должна быть протертой и легкоусвояемой, запрещается включать в рацион жареное и жирное, фрукты, соки и газированные напитки, молочные продукты. В дальнейшем проводится расширение возрастного рациона.
Эффективность проведенной комплексной терапии оценивают по клиническим критериям (купирование диареи, рвоты, интоксикационного синдрома, нормализация температуры) и клинико-лабораторным данным (отрицательные результаты при бактериологическом и ПЦР-обследовании, нормализация гемограммы, копроцитограммы).
Осложнения кишечных инфекций у детей
При тяжелых формах кишечных токсикозов у детей возможно развитие отека легких, острой почечной и острой сердечной недостаточности. Тяжелая дегидратация способствует развитию гиповолемического, инфекционно-токсического шока.
В мире ежегодно регистрируется примерно 2 млн летальных исходов от острых кишечных инфекций, преимущественно среди детей до 5 лет.
При развивающихся изменениях гемостаза возникает угроза развития синдрома диссеминированного внутрисосудистого свертывания крови.
Прогноз
Раннее выявление, грамотная предварительная диагностика, своевременное назначение адекватной терапии обеспечивают полное выздоровление.
Профилактика кишечных инфекций у детей
С целью предотвращения заболевания необходимо придерживаться санитарно-гигиенических норм.
Профилактика кишечных инфекций у детей проводится по всем звеньям эпидемической цепи:
- воздействие на источник инфекции – раннее выявление и своевременная изоляция больных, обследование контактных лиц, допуск в детские учреждения детей после перенесенных кишечных инфекций только при отрицательном результате бактериологического исследования;
- прерывание путей передачи инфекции – проведение дезинфекции в очагах инфекции, очистка от мусора, отбросов, борьба с насекомыми, контроль хранения, приготовления и транспортировки пищевых продуктов, надзор за источниками водоснабжения, воспитание санитарно-гигиенических навыков, соблюдение правил личной гигиены;
- повышение защитных сил организма – организация рационального питания, предупреждение инфекционных заболеваний.
Источники
- Григорьев К.И. Кишечные инфекции у детей. 2011. Медицинская сестра;
- Афтаева Лариса Николаевна, Мельников Виктор Львович, Аверкин Заболеваемость острыми кишечными инфекциями у детей. 2016. International scientific review;
- Жумагалиева Г.Д., Тураров О.С., Алманиязова С.Ж., Есенгалиева Н.Т. Этиологическая структура кишечных инфекций у детей. 2012. West Kazakhstan Medical Journal;
- Крамарев С.А. Лечение острых кишечных инфекций у детей. 2013. Здоровье ребенка;
- Кулиева З.М., Рустамова Лала Ислаховна, Азизова Н.А. Диагностика вирусных кишечных инфекций у детей. 2016. Российский медицинский журнал;
- Абатуров А.Е., Кривуша Е.Л., Герасименко О.Н., Ивашина В.И., Гирина И.А. Этиологическая структура кишечных инфекций у детей. 2010. Здоровье ребенка.
Видео с YouTube по теме статьи:
Об авторе

Диплом по специальности «Педиатрия», Санкт-Петербургский государственный педиатрический медицинский университет
Интернатура по специальности «Эндокринология», Кировская государственная медицинская академия
Информация является обобщенной и предоставляется в ознакомительных целях. При первых признаках болезни обратитесь к врачу. Самолечение опасно для здоровья!
Печень – это самый тяжелый орган в нашем теле. Ее средний вес составляет 1,5 кг.


























